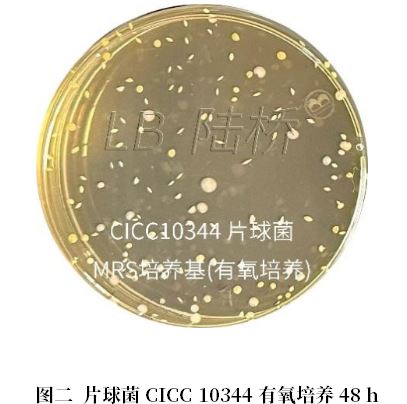
乳酸菌檢驗(yàn)新角色——片球菌屬與魏茨曼氏菌屬

2022年8月18日,國(guó)家衛(wèi)生健康委發(fā)布“關(guān)于《可用于食品的菌種名單》和《可用于嬰幼兒食品的菌種名單》更新的公告”��,新增了片球菌屬(Pediococcus)的乳酸片球菌和戊糖片球菌,以及魏茨曼氏菌屬(Weissella)凝結(jié)魏茨曼氏菌��。這兩類工業(yè)發(fā)酵菌在分類學(xué)上有所不同���,片球菌屬屬于革蘭氏陽(yáng)性球菌���,而魏茨曼氏菌屬則屬于芽胞桿菌。近些年來(lái)�����,部分生產(chǎn)企業(yè)已經(jīng)開始將片球菌屬與魏茨曼氏菌屬應(yīng)用于食品生產(chǎn)�。小編注意到已經(jīng)頒布的《2025年國(guó)家食品污染物和有害因素風(fēng)險(xiǎn)監(jiān)測(cè)工作手冊(cè)》中也增加了片球菌屬和魏茨曼氏菌屬的檢驗(yàn),但是大多數(shù)同行還從未見過(guò)這兩個(gè)新菌屬在分離計(jì)數(shù)培養(yǎng)基上的生長(zhǎng)狀態(tài)����,現(xiàn)在小編就與大家分享一下。
一����、片球菌屬

圖一 片球菌屬的檢驗(yàn)程序(依據(jù):《2025年國(guó)家食品污染和有害因素風(fēng)險(xiǎn)監(jiān)控工作手冊(cè)》)
作為食品生產(chǎn)菌種,片球菌屬通常有兩種應(yīng)用方式����,一是作為益生菌直接添加到食品中��,另一種則是作為菌種制劑的原料����。兩種應(yīng)用方式有所區(qū)別����,在檢驗(yàn)程序中樣品處理也有所區(qū)別,因此各位同行應(yīng)注意樣品的實(shí)際情況�����,根據(jù)不同的食品類型選擇不同的操作流程�����。
如果樣品中只添加片球菌屬或者添加的片球菌屬遠(yuǎn)高于其他微生物����,使用MRS瓊脂培養(yǎng)基進(jìn)行計(jì)數(shù)即可�����;如果樣品含有片球菌屬和其他菌株�,則需要使用改良MRS瓊脂培養(yǎng)基進(jìn)行計(jì)數(shù)����。MRS培養(yǎng)基想必大家都很熟悉了�����,絕大部分乳酸菌都能很好的生長(zhǎng)�。在這里的改良MRS瓊脂培養(yǎng)基,是額外添加了三種附加試劑:半胱氨酸鹽酸鹽為還原劑�,增強(qiáng)片球菌的抗氧化能力,使其在有氧條件下也能良好生長(zhǎng)����,新生霉素與萬(wàn)古霉素則是可以抑制非片球菌的生長(zhǎng),有利于片球菌的計(jì)數(shù)���。
下面是片球菌CICC 10344菌株分別傾注接種MRS培養(yǎng)基和改良MRS瓊脂培養(yǎng)基�����,36 ℃培養(yǎng)48 h的生長(zhǎng)狀態(tài)����。

圖五 MRS培養(yǎng)基,可配制成改良MRS瓊脂培養(yǎng)基
片球菌屬在MRS培養(yǎng)基上的形態(tài)與大多數(shù)乳酸菌相同���,并且在MRS培養(yǎng)基上與改良MRS瓊脂培養(yǎng)基上形態(tài)也沒有明顯區(qū)別�,均為灰白色菌落��,厭氧培養(yǎng)菌落會(huì)比有氧培養(yǎng)稍大�����。
二����、魏茨曼氏菌屬

圖六 魏茨曼氏菌屬的檢驗(yàn)程序(依據(jù):《2025年國(guó)家食品污染和有害因素風(fēng)險(xiǎn)監(jiān)控工作手冊(cè)》)
魏茨曼氏菌屬的檢驗(yàn)流程與片球菌屬類似,也同樣需要區(qū)分樣品類型����,但是這里多了一步傾注前熱激的步驟。根據(jù)相關(guān)資料�,小編推測(cè)原因如下:一方面魏茨曼氏菌屬具有耐熱性,經(jīng)過(guò)80 ℃水浴10 min�����,可以殺死絕大部分非魏茨曼氏菌屬的微生物���;另一方面���,魏茨曼氏菌屬屬于中度嗜熱菌,適當(dāng)?shù)臒峒た纱龠M(jìn)菌體代謝和休眠的芽胞萌發(fā)��,加速酶活性����,使得干燥樣品中的魏茨曼氏菌屬恢復(fù)其活力(如果若樣品水分含量較高,則不必進(jìn)行水浴熱激)��。
傾注使用的是魏茨曼氏菌屬計(jì)數(shù)瓊脂培養(yǎng)基(WCA)����,培養(yǎng)條件為需氧,40 ℃±2 ℃��,48 h±2 h��。下面是菌株CICC 24625傾注接種魏茨曼氏菌屬計(jì)數(shù)瓊脂培養(yǎng)基(WCA)�����,40 ℃有氧培養(yǎng)48 h的生長(zhǎng)狀態(tài)�。


圖八 魏茨曼氏菌屬計(jì)數(shù)瓊脂培養(yǎng)基(WCA)
魏茨曼氏菌屬在WCA上的形態(tài)為乳白色小菌落,傾注后在瓊脂內(nèi)部生長(zhǎng)的菌落不是梭狀,而是邊緣不規(guī)則的三角形���。
以上就是關(guān)于片球菌屬和魏茨曼氏菌屬在各自計(jì)數(shù)培養(yǎng)基上的形態(tài)介紹�,希望看過(guò)本文后��,各位同行對(duì)片球菌屬與魏茨曼氏菌屬有了一個(gè)初步認(rèn)識(shí)��,今后小編也會(huì)繼續(xù)跟大家分享微生物檢驗(yàn)的各種知識(shí)���,最后祝大家工作順利��。